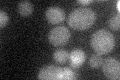
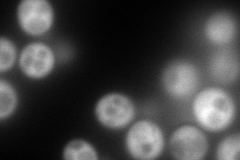
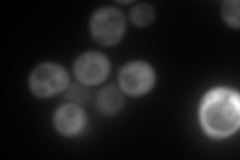

View description
Ran GTPase binding protein; involved in nuclear protein import and RNA export, ubiquitin-mediated protein degradation during the cell cycle; shuttles between the nucleus and cytoplasm; is essential; homolog of human RanBP1
Localization:
Intensity:
Fold change:
Significance:
-
C’ GFP library in SD
below threshold16.6 -
N' NOP1pr-GFP in SD
cytosol304.48 -
N' TEF2pr-mCherry in SD
cytosol348.477 -
N' NATIVEpr-GFP in SD

cytosol214.961 -
N' TEF2pr-VC and Cyto-VN in SD

#N/A0 -
C’ GFP library in SD+DTT

cytosol13.910.83No -
C’ GFP library in SD+H2O2

cytosol15.820.95No -
C’ GFP library in Starvation Media

cytosol18.531.11No -
C’ GFP library on the background of Pup2-DaMP

below threshold -
C’ GFP library on the background of CCT mutant

below threshold17.86221.07539No
